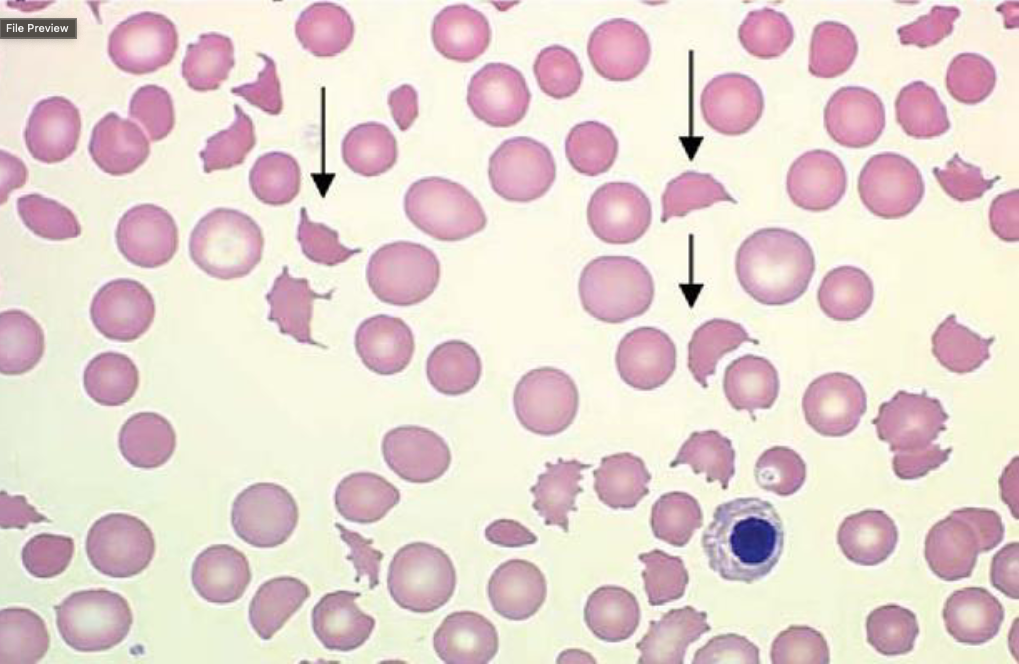
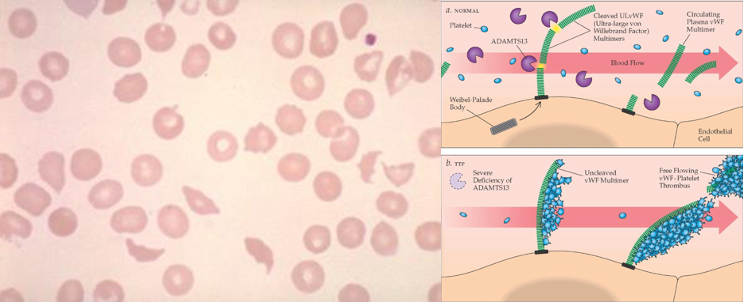

Primary hemostasis

Secondary hemostasis (coagulation cascades)

Laboratory Assessment of Platelets
- Platelet count (thrombocytopenia)
- Blood smear morphology (thrombocytopenia)
- Bleeding time (platelet function)
- PFA-100 (platelet function)
- Platelet aggregation studies (platelet function)
- Bone marrow examination (thrombocytopenia)
Laboratory Assessment of Coagulation
- PT (extrinsic/common pathway)
- aPTT (intrinsic/common pathway)
- Thrombin time (fibrinogen)
- Reptilase time (fibrinogen – heparin)
- Mixing studies (deficiency vs. inhibitor)
- Fibrinogen
- Factor assays (specific clotting factors)
- Stypven time (factor VII)
- DRVVT (phospholipid antibodies, lupus
anticoagulant) - Clot solubility (factor XIII)
- D-dimer (fibrinolysis following thrombosis)
Case 1
- A six-year-old boy, while playing catcher, was struck on the arm by a foul ball.
- The appearance of his arm is shown on the next slide.
- He was admitted to a local hospital earlier today.
- The hematoma was drained.
- During and after the operation, he bled profusely and required transfusion with 4 units of PRBC.
- A prothrombin time (PT) performed in the operating room was normal.
- He is transferred to your medical center for further diagnosis and management.
What conclusions, if any, can be drawn about the nature of his bleeding at this point?
What additional history would you like to obtain?
What additional testing would you like to obtain?

What conclusions, if any, can be drawn about the nature of his bleeding at this point?
extrinsic or common pathway is intact
when did they do the blood tests? before or after they gave PRBC’s
inherited?
normal PT, no deficiency of factors 7, 10, 5, 2, or 1
What additional history would you like to obtain?
family history of bleeding disorder
personal history of bleeding disorder
PTT
medications
evidence of liver disease?
splenomegaly
renal disease
info:
bleeds longer than his peerts with scrapes
no previous surgery
not circumcised
no FH of bleeding
acetaminophen prn
healthy
What additional testing would you like to obtain?
aPTT
platelet count
bleeding time or PFA-100
1. if family history is unknown or suggestive of cWD
2. if CBC, PT, aPTT, all normal
3. if vWD or platelet dysfunction is suspected
ptt is 52 seconds
platelet count 327,000
bleeding time is 6.5 minutes, (normal <8.5 minutes)
Diagnosis:
What are his hemostatic abnormalities?
isolated prolongation of his PTT, normal PT, platelet count, and bleeding time
traumatic hematoma
What are the possible mechanisms for his prolonged PTT?
Inherited factor deficiency
vWD (unlikely because of normal platelets)
circulating inhibitor of his coagulation cascade
How can we distinguish these?
Mixing studies - either PT or PTT
lack of correction in mixing studies suggests an inhibitor
correction in mixing studies suggests factor deficiency
aPTT, baseline 52 seconds
contol aPTT 29 seconds
aPTT after mixing 33s
correction in mixing studies suggests factor deficiency
could be factor 8, 9, 11, or 12 - in intrinsic pathway
could be VWD
of the factors, factor 8 is most common
Case 1
* The patient’s mother is now much calmer and can give a more detailed family history.
* The patient’s male cousin bled for 2 days after dental extraction.
* Family pedigree is shown.
Possible diagnoses?
* Factor VIII activity
* 9%
* Factor IX activity
* 105%
* Factor XI activity
* 100%
* vWF activity
* 98%
* vW antigen
* 103%
* Ristocetin-induced
platelet aggregation
* normal
What is your diagnosis?
* Mild hemophilia A (factor VIII deficiency)
What would yourecommend to preventthis from happening in the future?
- Prevent trauma
- DDAVP or rH-VIII prior to high risk activities
- Avoid aspirin

Case 2
- A 35 year-old man is brought to the Emergency Department in an unconscious state after being discovered in a boarding house that had been the site of a serious fire
- Approximately 70% of his body surface is covered by second and third-degree burns
- His vital signs include: temperature - 104oF, P - 175, R - 28, BP - 70/50.
- Initial laboratory studies included: PT – 18 seconds,
aPTT – 49 seconds, and platelet count – 27,000/μL. - When blood was drawn, there was significant oozing of blood from venipuncture sites
What abnormalities are present?
What additional history would you like to obtain?
What additional testing would you like to obtain?
What abnormalities are present?
* Prolonged PT
* Prolonged aPTT
* Thrombocytopenia
What additional history would you like to obtain?
* No prior bleeding
history
* No family history of
bleeding
* No medications
What additional testing would you like to obtain?
* Blood smear morphology
* Fibrinogen – 110 mg/dl
* D-dimer - positive
Diagnosis:
* What is the most likely diagnosis?
Disseminated intravascular coagulation (DIC) secondary to massive burn injury
Case 3
- A 42-year-old woman presents with recent onset of right upper quadrant pain
- An abdominal ultrasound is performed and demonstrates numerous small gallstones with dilatation of the cystic duct. She was referred to a surgeon for cholecystectomy.
- Pre-operative laboratory evaluation included: PT
- 12 seconds, aPTT - >200 seconds, platelet count
– 250,000/μL, and bleeding time – 6.5 minutes - She is subsequently referred to a Hematologist for further evaluation prior to surgery.
What abnormalities are present?
What additional history would you like to obtain?
What additional testing would you like to obtain?
What abnormalities are present?
* Prolonged aPTT
* Normal PT, platelet count, and bleeding time
What additional history would you like to obtain?
* No current bleeding
* Surgery: Tonsils (6), C- section (28), hemorrhoids (38) – all with no bleeding
* No family history of bleeding
* No medications, except for remote aspirin use
* No adenopathy or organomegaly
What additional testing would you like to obtain?
* aPTT mixing study – 40
seconds
* Factor VIII level – 95%
* Factor IX level – 102%
* Factor XI level – 98%
* Factor XII level - <1%
Diagnosis:
* Hereditary factor XII deficiency
Case 4
- A 5 year-old boy presents with a marked bruising tendency in his arms and legs, which his mother says is not related to “significant” trauma.
- At age 3, the patient had an episode of severe epistaxis, which required hospital admission, transfusion of one unit of packed RBCs, and nasal packing to control the bleeding
- Laboratory testing included: PT – 12 seconds, aPTT – 43 seconds, platelet count – 360,000/μL, and bleeding time - >10 minutes
What abnormalities are present?
What additional history would you like to obtain?
What additional testing would you like to obtain?
What abnormalities are present?
* Minimally prolonged aPTT
* Prolonged bleeding time
* Normal PT and platelet count
What additional history would you like to obtain?
* Circumcised – no bleeding
* Eye surgery for strabismus (20 months) – no bleeding
* Maternal-side bleeding (mother, grandmother, great grandmother) – epistaxis, easy bruising, menorrhagia
* Mother required 9 units PRBC at time of delivery
* No medications
What additional testing would you like to obtain?
* Factor VIII activity – 28%
* vWF activity – 30%
* vWF antigen – 34%
* Platelet aggregation
(results shown on next
slide)
Diagnosis:
* von Willebrand Disease
(type I)

Case 5
- A 68-year-old woman presents with abdominal cramping and bloating for three days, which is accompanied by bloody diarrhea
- She also noticed gradual onset of weakness and
“easy bruising” over the past six months - Physical examination demonstrates large ecchymoses over her arms and legs
- Laboratory testing includes: PT – 19 seconds, aPTT – 83 seconds, and platelet count – 157,000/μL
What abnormalities are present?
What additional history would you like to obtain?
What additional testing would you like to obtain?
What abnormalities are present?
* Prolonged PT
* Prolonged aPTT
* Low normal platelet count
What additional history would you like to obtain?
* No history of bleeding
* Negative family history for bleeding
* Osteoarthritis for the past 10 years
* NSAIDs for arthritis
* Liver palpable 4 cm below RCM
* Spleen not palpable
What additional testing would you like to obtain?
* Hgb – 10.7 g/dL
* ALT/AST – normal
* Alk Phos – 220 U/mL
* PT mixing study – 12 seconds
* aPTT mixing study – 40 seconds
* Stypven time – 24 seconds (nl 6-10 sec)
- Fibrinogen – 280 mg/dl
- Factor II level – 95%
- Factor V level – 103%
- Factor X level – 5%
- Rectal biopsy (shown on next slide)
Diagnosis:
Acquired factor X deficiency secondary to amyloidosis

Case 6
- A 56-year-old woman presents with abdominal pain
accompanied by nausea and vomiting for the past 3-4
weeks - She also admits to increasing food intolerance and post-prandial epigastric pain for the past year
- Physical examination demonstrates abdominal distention, decreased bowel sounds, and rebound tenderness
- She has been taking aspirin regularly to help relieve her
abdominal pain - Laboratory studies include: PT – 19 seconds, aPTT – 48
seconds, platelet count – 180,000/μL, and bleeding
time – 9.5 minutes.
What abnormalities are present?
What additional history would you like to obtain?
What additional testing would you like to obtain?
What abnormalities are present?
* Prolonged PT
* Prolonged aPTT
* Prolonged bleeding time
* Normal platelet count
What additional history would you like to obtain?
* No history of surgery
* No bleeding during pregnancies/deliveries
* Negative family history for bleeding
* Recent course of antibiotics for an upper respiratory tract infection
- The patient was admitted and had an upper endoscopy, which demonstrated a perforated gastric ulcer
- The patient emergently underwent partial gastrectomy and post-operatively became hypotensive with bleeding noted at the surgical site
What additional testing would you like to obtain?
* PT mixing study – 13 seconds
* aPTT mixing study – 40 seconds
* Factor X level – 25%
* Factor VII level – 10%
* Factor V level – 90%
* Platelet aggregation with arachidonic acid - reduced
Diagnosis:
* Vitamin K deficiency
* Qualitative platelet defect secondary to aspirin
Case 7
- A 19-year-old woman presents with skin rash.
- The appearance of her rash is shown on the
next slide. - The spleen is not palpable and there is no
lymphadenopathy - Neurologic exam is normal
- Her CBC includes: WBC 7,800/μL (70% PMN,
25% lymphs, 3% monocytes, 2% eosinophils),
hemoglobin 14.2 g/dL, and platelets 3,000/μL.
What abnormalities are present?
What additional history would you like to obtain?
What additional testing would you like to obtain?

What abnormalities are present?
White Blood Cell Count (WBC):
The total WBC count is within the normal range, indicating a generally normal immune system response.
The differential count shows the percentage distribution of different types of white blood cells, and the values seem to be within the normal ranges as well.
Hemoglobin:
The hemoglobin level of 14.2 g/dL is within the normal range. Hemoglobin is a protein in red blood cells that carries oxygen.
Platelet Count:
The platelet count is extremely low at 3,000/μL. Normal platelet counts typically range from 150,000 to 450,000/μL. A platelet count of 3,000 is significantly below the normal range.
What additional history would you like to obtain?
* Previous history of thrombocytopenia
no
* Symptoms of connective tissue disease
no
* Medications
none
* Alcohol use
occasional
* Tonic water ingestion
no
* Recent viral infection
no
* History of hepatitis
no
* HIV risk factors
sexually active
* Neurologic symptoms
none
What additional testing would you like to obtain?
* Repeat platelet count -
2,000/ul
abnormally low platelet count (thrombocytopenia)
* Blood smear (shown on
next slide)
* What are the possible mechanisms for her thrombocytopenia?
* Spurious
Platelet clumping
* True
Decreased production
Ineffective production
Sequestration
Increased utilization
Increased destruction
* Differential diagnosis of isolated thrombocytopenia in a healthy young female?
* ITP
* Autoimmune disease (e.g. SLE)
* Hepatitis C
* HIV
* Myelodysplasia
* Acute leukemia
- Hepatitis C antibody
neg - ANA
neg - HIV
non reactive - Antiplatelet antibodies
1500/pL (nl <300) - Bone marrow aspiration and biopsy (image bot)
Diagnosis:
Idiopathic/Immune
thrombocytopenic purpura (ITP)
Some hematologists would argue that all of the above tests (including the bone marrow) are superfluous to make the diagnosis of ITP, except for the HIV, hepatitis and ANA serologies
* Should therapy be started?
* Spontaneous remission is rare in adult ITP when
compared to ITP in children
* Risk of CNS hemorrhage is 4-5%
* Observation is appropriate in children
- Prednisone:
1 mg/kg/day - Dexamethasone:
40 mg/d x 4d - She responded uneventfully to prednisone

Case 8
- A 54-year-old male has spinal stenosis secondary to a work-related injury
- He is scheduled for laminectomy and spinal fusion to improve his pain and ability to walk
- Preoperative screening by his surgeon demonstrates a normal CBC, PT, and aPTT
- His bleeding time is > 20 minutes
- He is referred for hemostatic clearance prior to surgery
What abnormalities are present?
What additional history would you like to obtain?
What additional testing would you like to obtain?
What abnormalities are present?
* Prolonged bleeding time with normal PT, aPTT, and platelet count
What additional history would you like to obtain?
* Bleeding with prior surgery or procedures
“Nearly bled to death after vasectomy”, but back to work 3 days later
* Family history of bleeding
none
* Medications
none
* History of hepatic or renal disease
Drank heavily in the past, “occasionally” now
What additional testing would you like to obtain?
* Factor VIII level – 96%
* vWF activity – 105%
* vWF antigen – 100%
* Platelet aggregation studies (shown on next slide)
* Platelet electron microscopy (shown on subsequent slide)
Diagnosis:
* Storage pool disorder
(dense granule deficiency)

Case 9
- A 62-year-old woman presents with recent onset of confusion, which is somewhat episodic
- Her symptoms have increased significantly over the past several days and she is currently incoherent
- Physical examination demonstrates several large bruises over her legs
- Laboratory studies include: PT – 12 seconds, aPTT
– 40 seconds, and platelet count – 48,000/μL
What abnormalities are present?
What additional history would you like to obtain?
What additional testing would you like to obtain?
What abnormalities are present?
* Decreased platelet
count
* Normal PT and aPTT
What additional history would you like to obtain?
* No history of bleeding or thrombocytopenia
* Negative family history for bleeding
* Adult-onset diabetes managed with oral hypoglycemic agents and diet
What additional testing would you like to obtain?
* Hgb -6.9 g/dL
* Retic count – 4.5%
* Creatinine – 2.8 mg/dL
* Blood smear (shown on next slide)
* D-dimer – negative
* ADAMTS-13 activity - decreased
Diagnosis:
* Thrombotic thrombocytopenic purpura (TTP)
Case 10
- A 23-year-old man was seen by an orthopedic surgeon for a left knee injury he sustained while playing basketball
- Physical examination demonstrates a swollen and discolored left knee
- Aspiration of the left knee yielded a large amount of bloody synovial fluid
- Laboratory data included: PT – 11 seconds, aPTT
– 35 seconds, platelet count – 200,000/μL,
bleeding time – >15 minutes.
What abnormalities are present?
What additional history would you like to obtain?
What additional testing would you like to obtain?
What abnormalities are present?
* Prolonged bleeding time
* Normal PT, aPTT, and platelet count
What additional history would you like to obtain?
* At birth covered with petechiae (nl platelets)
* As child, frequent epistaxis (2-3 days)
* Age 5 – fell, abdominal trauma, internal bleeding
* Teens – less epistaxis, petechiae
* Played basketball/baseball, swelling of knees and elbows
* Gingival oozing after brushing teeth
* Appendectomy – minimal bleeding
* Maternal grandfather and female cousin with bleeding history, 4 siblings – no bleeding
What additional testing would you like to obtain?
* Factor VIII level – 100%
* vWF activity – 100%
* vWF antigen – 120%
* Platelet aggregation studies (shown on next page)
* Clot retraction – absent
Diagnosis:
Glanzmann thrombasthenia



